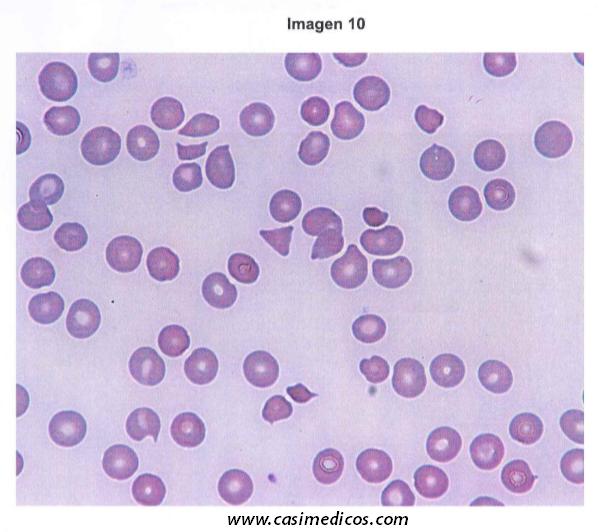

Anuncio
Respuestas cortesía de Irene y @yebeness
Pregunta 10:
Una mujer de 40 años acude al servicio de urgencias por síndrome anémico. En la exploración física se observa palidez mucocutánea con tinte ictérico en conjuntivas. En los análisis de sangre periférica destacan los siguientes datos: leucocitos 7380/μL, hemoglobina 7,6 g/dL, VCM 97 fl, plaquetas 78.000/μL, LDH 1092 U/L, bilirrubina total 3,4 mg/dL y bilirrubina indirecta 2,9 mg/dL. Ante los hallazgos del frotis de sangre periférica, indique el diagnóstico de sospecha correcto:
Una mujer de 40 años acude al servicio de urgencias por síndrome anémico. En la exploración física se observa palidez mucocutánea con tinte ictérico en conjuntivas. En los análisis de sangre periférica destacan los siguientes datos: leucocitos 7380/μL, hemoglobina 7,6 g/dL, VCM 97 fl, plaquetas 78.000/μL, LDH 1092 U/L, bilirrubina total 3,4 mg/dL y bilirrubina indirecta 2,9 mg/dL. Ante los hallazgos del frotis de sangre periférica, indique el diagnóstico de sospecha correcto:
Anemia hemolítica autoinmune
Mielofibrosis
Anemia hemolítica microangiopática
Anemia drepanocítica
Índice de contenidos
Correct!
Wrong!
Pregunta 11:
Hombre de 68 años que consulta por astenia. Refiere dolores óseos como única sintomatología acompañante. Su función renal era normal 6 meses antes.
Se realiza analítica general que muestra: creatinina 2,0 mg/dl, urea 86 mg/dL, proteínas plasmáticas 90 g/L, VSG 120 mm/h, ratio albumina/creatinina urinaria 4 (normal), ratio proteína/creatinina urinaria 80 (N<22). Se adjunta la imagen del sedimento de orina y de la tira reactiva de orina.
¿Qué sospecha que pueda tener el paciente y qué prueba haría en primer lugar?
Hombre de 68 años que consulta por astenia. Refiere dolores óseos como única sintomatología acompañante. Su función renal era normal 6 meses antes.
Se realiza analítica general que muestra: creatinina 2,0 mg/dl, urea 86 mg/dL, proteínas plasmáticas 90 g/L, VSG 120 mm/h, ratio albumina/creatinina urinaria 4 (normal), ratio proteína/creatinina urinaria 80 (N<22). Se adjunta la imagen del sedimento de orina y de la tira reactiva de orina.
¿Qué sospecha que pueda tener el paciente y qué prueba haría en primer lugar?

Una amiloidosis y haría una biopsia de grasa subcutánea.
Un mieloma multiple y pediría un proteinograma y proteína de Bence Jones en orina.
Una enfermedad glomerular y solicitaría una biopsia renal urgente.
Una necrosis tubular aguda y solicitaría una ecografía renal
Correct!
Wrong!
Pregunta 106:
Mujer de 40 años que consulta por anemia. En la analítica destaca Hb 10,5 g/dL, ferropenia, macrocitosis e hipergrastrinemia. Tiene antecedentes artropatía lúpica y enfermedad de Graves Basedow. Está en tratamiento con prednisona 15 mg/d, colchicina 0,5 mg cada 12 horas y metimazol 10mg/d. ¿Cuál considera la causa más probable de la anemia?
Mujer de 40 años que consulta por anemia. En la analítica destaca Hb 10,5 g/dL, ferropenia, macrocitosis e hipergrastrinemia. Tiene antecedentes artropatía lúpica y enfermedad de Graves Basedow. Está en tratamiento con prednisona 15 mg/d, colchicina 0,5 mg cada 12 horas y metimazol 10mg/d. ¿Cuál considera la causa más probable de la anemia?
Pérdidas hemáticas en relación con el tratamiento esteroideo
Hipoplasia medular 2º a colchicina
Hemólisis secundaria a la toma de metimazol
Gastritis tipo A
Correct!
Wrong!
Pregunta 107:
Una mujer de 32 años de edad consulta porque desea quedar embarazada y refiere antecedentes de episodio de embolia de pulmón 7 años antes mientras estaba tomando anticonceptivos orales. Se realizó tratamiento con acenocumarol durante 6 meses. El estudio de trombofilia fue negativo. Se aconseja realizar profilaxis de trombosis venosa en el caso de que quede embarazada. Señale la respuesta correcta:
Una mujer de 32 años de edad consulta porque desea quedar embarazada y refiere antecedentes de episodio de embolia de pulmón 7 años antes mientras estaba tomando anticonceptivos orales. Se realizó tratamiento con acenocumarol durante 6 meses. El estudio de trombofilia fue negativo. Se aconseja realizar profilaxis de trombosis venosa en el caso de que quede embarazada. Señale la respuesta correcta:
Debe aconsejarse tratamiento profiláctico con heparina de bajo peso molecular durante el embarazo y hasta 6 semanas posparto.
Debe aconsejarse tratamiento profiláctico con aspirina durante todo el embarazo.
Debe aconsejarse realizar profilaxis con acenocumarol durante todo el embarazo.
Dado que el estudio de trombofilia fue negativo solo se precisa realizar profilaxis de trombosis venosa con medias compresivas para miembros inferiores.
Correct!
Wrong!
Pregunta 108:
Respecto al tratamiento anticoagulante indique la repuesta FALSA:
Respecto al tratamiento anticoagulante indique la repuesta FALSA:
Dabigatrán- Inhibidor directo de la trombina
Plasugrel-Inhibidor de agregación y activación plaquetaria
Edoxabán-Inhibidor directo
Idarucizumab- Inhibidor de la activación del plasminógeno
Correct!
Wrong!
Pregunta 109:
Hombre de 35 años con leucemia mieloide aguda sometido a alotrasplante de progenitores hematopoyéticos con acondicionamiento mieloablativo. Se encuentra en tratamiento con tacrolimus en rango terapeútico y profilaxis con aciclovir y un azol. Estando ambulatorio y sin complicaciones previas, acude al hospital en el día +24 postrasplante con eritema cutáneo generalizado que afecta con mayor intensidad a palmas y plantas, cara cuello, tronco, flancos y cara interna de los muslos. Es de reciente aparición (24-48 horas) y se acompaña de anorexia, naúseas, diarrea acuosa y dolor abdominal. ¿ Cuál es la actitud terapeútica más adecuada?
Hombre de 35 años con leucemia mieloide aguda sometido a alotrasplante de progenitores hematopoyéticos con acondicionamiento mieloablativo. Se encuentra en tratamiento con tacrolimus en rango terapeútico y profilaxis con aciclovir y un azol. Estando ambulatorio y sin complicaciones previas, acude al hospital en el día +24 postrasplante con eritema cutáneo generalizado que afecta con mayor intensidad a palmas y plantas, cara cuello, tronco, flancos y cara interna de los muslos. Es de reciente aparición (24-48 horas) y se acompaña de anorexia, naúseas, diarrea acuosa y dolor abdominal. ¿ Cuál es la actitud terapeútica más adecuada?
Suspender lo antes posible el tratamiento inmunosupresor con tacrolimus
Iniciar tratamiento con esteroides a dosis altas.
Iniciar infusión de linfocitos del donante.
Iniciar tratamiento con fotoaféresis extracorpórea.
Correct!
Wrong!
Pregunta 110:
Mujer de 64 años, con antecedente de túnel carpiano bilateral. Presenta en los últimos meses un cuadro de astenia y disnea progresiva, hasta hacerse de pequeños esfuerzos. En la analítica destaca un pro-BNP de 2500 pg/mL, así como la existencia de un componente monoclonal (inmunofijación positiva para cadenas lambda) en suero de 0,4 g/dL. Los niveles de cadenas ligeras libres kappa y lambda son 1,2 y 67,8 mg/dL, respectivamente. Se realiza una punción esternal observándose una plasmocitosis medular del 6%. Ausencia de lesiones líticas en TC de esqueleto entero. ¿Cuál es el diagnóstico de sospecha y la prueba diagnóstica inicial para su confirmación?
Mujer de 64 años, con antecedente de túnel carpiano bilateral. Presenta en los últimos meses un cuadro de astenia y disnea progresiva, hasta hacerse de pequeños esfuerzos. En la analítica destaca un pro-BNP de 2500 pg/mL, así como la existencia de un componente monoclonal (inmunofijación positiva para cadenas lambda) en suero de 0,4 g/dL. Los niveles de cadenas ligeras libres kappa y lambda son 1,2 y 67,8 mg/dL, respectivamente. Se realiza una punción esternal observándose una plasmocitosis medular del 6%. Ausencia de lesiones líticas en TC de esqueleto entero. ¿Cuál es el diagnóstico de sospecha y la prueba diagnóstica inicial para su confirmación?
Macroglobulinemia de Waldenström-Analísis molecular del gen MYD88
Mieloma múltiple sintomático-PET/TC
Amiloidosis AL- Aspirado/biopsia de grasa abdominal
Síndrome de POEMS- Determinación de VEGF
Correct!
Wrong!
Pregunta 111:
Mujer de 17 años que presenta desde la primera menstruación reglas muy abundantes. Refiere epistaxis frecuentes. Hematimetría: Hb 10,5 g/dL, VCM 77fL, leucocitos 7200/μL con formula normal, plaquetas 182.000/μL. Tiempo de protrombina 12” (12”), TTPa 34” (30”), fibrinógeno 340 mg/dL. Agregación plaquetaria con ADP, colágeno y epinefrina: ausencia de respuesta. Aglutina con ristocetina. En citometría se observa ausencia de Gp IIb-IIIa. ¿Cuál es el diagnóstico?
Mujer de 17 años que presenta desde la primera menstruación reglas muy abundantes. Refiere epistaxis frecuentes. Hematimetría: Hb 10,5 g/dL, VCM 77fL, leucocitos 7200/μL con formula normal, plaquetas 182.000/μL. Tiempo de protrombina 12” (12”), TTPa 34” (30”), fibrinógeno 340 mg/dL. Agregación plaquetaria con ADP, colágeno y epinefrina: ausencia de respuesta. Aglutina con ristocetina. En citometría se observa ausencia de Gp IIb-IIIa. ¿Cuál es el diagnóstico?
Tromboastenia de Glanzmann
Enfermedad de von Willebrand
Trombocitopenoa inmune primaria
Síndrome de Bernard-Soulier
Correct!
Wrong!
Pregunta 112:
Una joven de 23 años es referida por su obstetra para estudio de trombocitopenia. Sus plaquetas en la primera evaluación prenatal fueron de 42.000/μL. Esta emabarazada de 16 semanas y no refiere manifestaciones hemorrágicas. La exploración física es normal. Hemograma: leucocitos 8500/ μL, Hb 12 g/dL, plaquetas 51000/μL. La revisión del fortis sanguíneo revela plaquetas en acúmulos. ¿Cuál es la sospecha diagnóstica?
Una joven de 23 años es referida por su obstetra para estudio de trombocitopenia. Sus plaquetas en la primera evaluación prenatal fueron de 42.000/μL. Esta emabarazada de 16 semanas y no refiere manifestaciones hemorrágicas. La exploración física es normal. Hemograma: leucocitos 8500/ μL, Hb 12 g/dL, plaquetas 51000/μL. La revisión del fortis sanguíneo revela plaquetas en acúmulos. ¿Cuál es la sospecha diagnóstica?
Trombocitopenia inmune primaria
Trombocitopenia del embarazo
Seudotrombocitopenia por EDTA
Púrpura trombótica trombocitopénica.
Correct!
Wrong!
Pregunta 113:
Con respecto al trasplante de progenitores hematopoyéticos señale la afirmación FALSA:
Con respecto al trasplante de progenitores hematopoyéticos señale la afirmación FALSA:
En pacientes que carecen de un donante familiar o no emparentado HLA-idéntico se puede emplear la sangre de cordón umbilical como fuente alternativa.
En pacientes que carecen de un donante familiar o no emparentado HLA-idéntico se puede emplear células progenitoras de un donante haploidéntico
En el trasplante autólogo las células se encuentran criopreservadas y han de descongelarse previo a su administración.
El efecto injerto contra leucemia es mayor en el trasplante autólogo que en el alogénico.
Correct!
Wrong!
Share the quiz to show your results !
Subscribe to see your results
Respuestas Hematología examen MIR 2018
Obtuve %%score%% de %%total%%
%%description%%
%%description%%
Loading...
Estas respuestas no son las oficiales ( las actualizaremos con las mismas en cuanto salgan) sólo reflejan la opinión de aquellos voluntarios que han elegido participar en la Iniciativa MIR 2.0 de respuesta al examen MIR.
Te animamos a que compartas esta pagina con tus amig@s. Puedes comentar sobre este tema en el foro y/o en los comentarios de esta entrada.
LAS RESPUESTAS TAMBIÉN SE PUBLICARÁN EN LOS DIFERENTES BLOGS DE LOS PROFESIONALES QUE PARTICIPAN EN LA INICIATIVA.
OS PEDIMOS DESDE AQUÍ LA MÁXIMA DIFUSIÓN A LA INICIATIVA PARA QUE LLEGUE AL MÁXIMO DE OPOSITORES MIR PRESENTES Y FUTUROS PARA QUE LES SEA DE AYUDA.
¿Qué te ha parecido?¿Te resultó útil? Si así fuera, compártelo para que se difunda y nos apoyemos entre nosotros, los casiMedicos, ¡gracias!
Puedes dejarme tus comentarios abajo.





